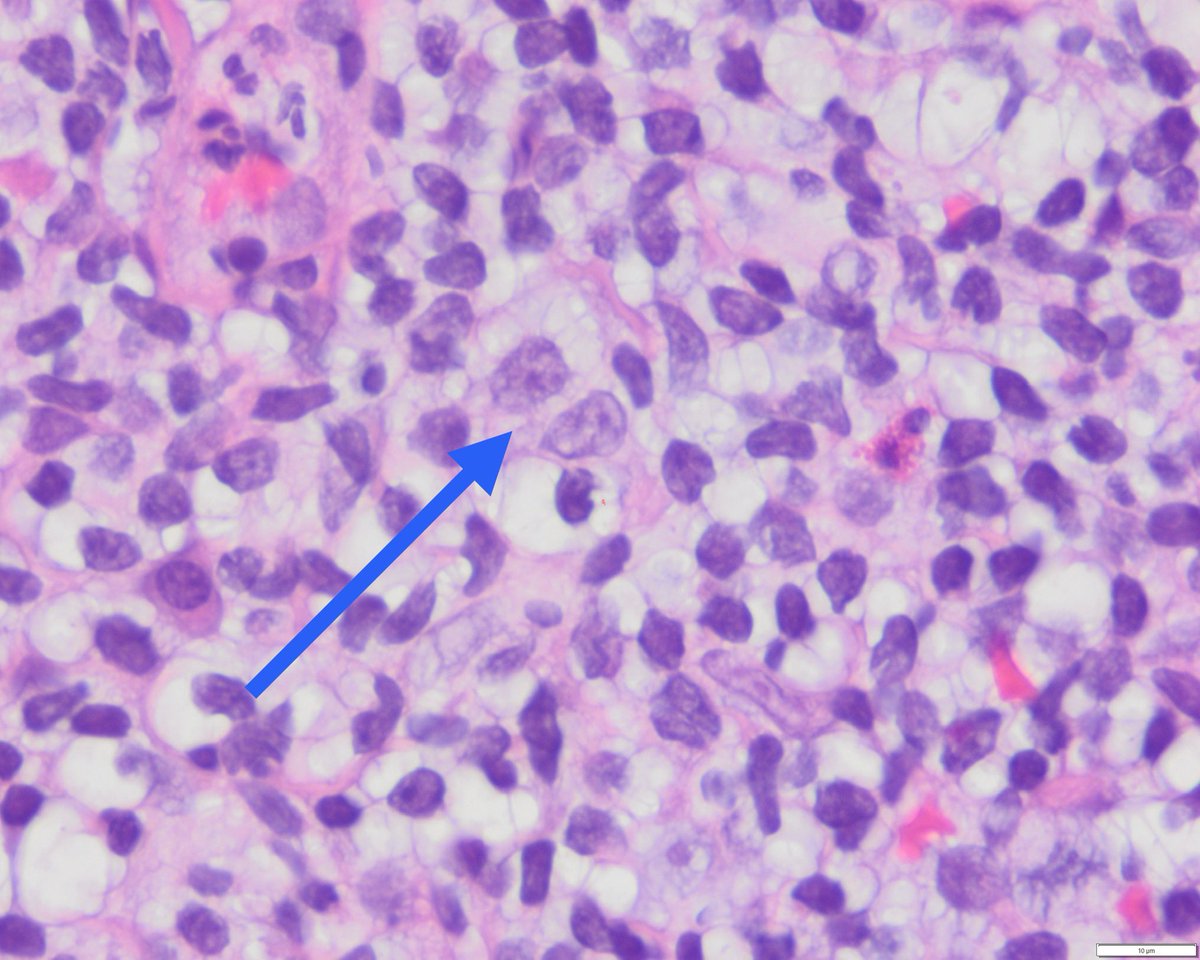

Sadhika Sood
@sadhikasood
PGY-2 AP/CP @NYUGSOM_path | @TheUSCAP Ambassador 2025-27 |
Dean's MPH Scholar @JohnsHopkinsSPH | MBBS @KMC_Mangalore
ID: 1506995856972857344
24-03-2022 14:06:43
104 Tweet
208 Followers
400 Following




Had a highly productive morning attending the Association for Molecular Pathology and Renal Pathology Society meetings at #USCAP2025! Great discussions and insights—looking forward to more engaging sessions ahead! #PathX #PathTwitter USCAP


This is it people…. It’s really happening One unified #hemepath classification in the works…WHO 6th coming to you soon SocforHemepath #USCAP2025




The NYU GSOM Pathology crew showed up strong this year for #USCAP2025 So proud of our team for the work, the energy, and the way we show up for each other. 💜 🔬 #PathTwitter




2025 Atlantic Regional HematoPathology Meeting is taking place this week NYU GSOM Pathology in NYC! Don’t miss it! Organized by our own Chris Park, MD/PhD. NYU Grossman School of Medicine #pathology #hemepath #heme


Excited to be delivering a joint session with Dr. Wei Wang ICCS_Education about flow cytometry profiling of plasmacytoid dendritic cell neoplasms/ proliferations, on Monday May 19th at noon ET! Link to register➡️ shorturl.at/E5Zh5 #Hemepath #MPNsm #Leusm #MDSsm #BPDCNsm


Dr. Park kicks off the 2025 Atlantic Regional Hematopathology Meeting on “Emerging Technologies and Approaches in Hematopathology”! Grateful to attend this incredible event at my future home institution, NYU GSOM Pathology ✨ #hemepath #PathTwitter #pathx


we have so much data but the most fierce 2 stats about NYU GSOM Pathology Digital Pathology transformation are: Surg Path cases digitized: 5/12/24: 0% 5/12/25: 100% Surg Path cases SIGNED OUT digitally: 5/12/24: 0% 5/12/25: ~70% (!) #pathtwitter #digitalpathology

Had an amazing time at the SocforHemepath Experimental Hemepath meeting at NYU GSOM Pathology last week — inspiring science, thought-provoking discussions, and a truly welcoming community! 🧬Grateful to be part of it. Counting down to the SH-EA4HP Workshop this September!





📢Call for Proposals! Department of Health Research, MoHFW invites applications for Support to Institutions. 👩🔬For institutions and scientific professionals/bodies /associations 📝Apply Now: shorturl.at/OWNgQ 📘Guidelines: shorturl.at/JjaPm 📅Deadline: 31 May 2025 #Research #Grants


Announcing the next dean of Johns Hopkins University Bloomberg School of Public Health, Keshia Pollack Porter! A champion for public health, Dr. Pollack Porter has distinguished herself as a leader in advancing policy change that promotes safe, healthy environments.